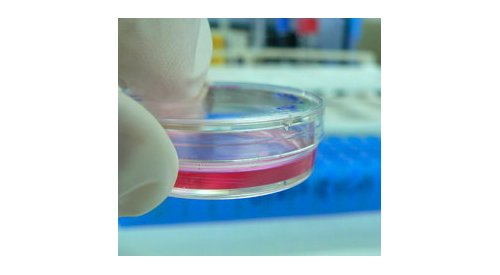

Laws & regulations
Tax on cosmetics: French trade association claims a first victory
In its fight against the taxation of cosmetic companies’ turnover, passed by the French parliament last year, the French trade...
Three proposals compete to amend U.S. cosmetics legislation
There is apparently a consensus between US lawmakers, the industry and the consumers on the need to modernize rules governing cosmetic...
"The tax on the cosmetic industry is unconstitutional," Alain Grangé-Cabane, FEBEA
It is not because the French cosmetic industry regularly posts a balance of trade clearly in surplus that it must be seen as the "goose...
Cosmetics for children: The Council of Europe recommends more precautions
Cosmetics intended for children under three years must be subject to particular precautions due to the increased risks of exposure...
How the total ban on animal testing will impact the cosmetics industry?
In March 2013 the total ban on animal testing for the cosmetics industry is due to be finalised. From this point on, it will be illegal...
Russia: The new cosmetic regulations will soon come into force
The Technical Regulation on the safety of cosmetic products adopted as part of the Customs Union between Russia, Belarus and...
Animal testing: The other serial of the season
The European Commission should eventually decide to leave the door open to some animal testing by granting exceptions to the absolute...
European cosmetics Regulation: a challenge for SMEs
The implementation of the new European Regulation on cosmetic products, which will come into force in July 2013, was the focus of...
"The new European Regulation on cosmetics is going to change our way of working!" Sylvain-Romain...
Dr. Sylvain-Romain Cotte, a specialist in cosmetic regulations, founder and director of SRC Consulting, is about to launch a new...
French health agency asks for lower aluminium concentration in cosmetics
Based on new scientific data, the French Health Products Safety Agency (Afssaps) recommends lowering the maximum allowed concentration...